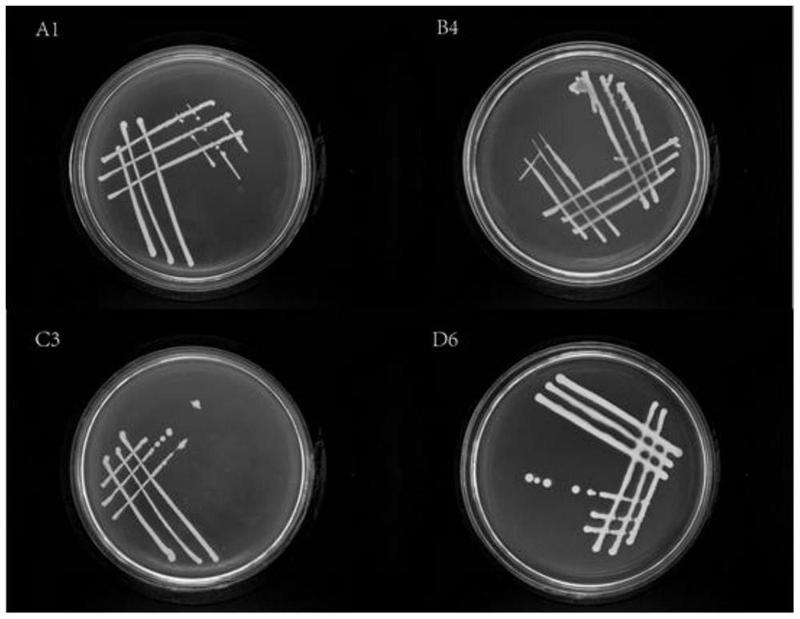
富硒产品的供给方式是（硒的供给来源）-硒宝网

富硒产品的供给方式是(硒的供给来源)
1、引言
硒元素是人体必需的微量元素,参与合成多种含硒酶和含硒蛋白。富硒农产品是硒元素含量较为丰富的农产品,能提高人体免疫力。富硒农产品主要分为富硒谷类、富硒肉类、富硒果蔬类、富硒蛋类等,科学研究表明硒富硒农产品可以有效预防疾病。人体内摄取的硒元素来源于日常饮食,而食物中硒含量直接影响人们日常硒的摄入量。由于受环境、土壤、气温等条件限制,大部分富硒农作物来自于人为添加硒肥的富硒产品种植企业。因此富硒农产品的研究、开发为缺硒和补硒人群提供了便利,并且间接促进农产品的质量安全,改善其农产品品质。
在富硒农产品研究方面陈夏、陈绪敖等人做了富硒品牌创建的影响因素及路径、特色农产业集群研究,得出了市场监管力度、企业主体的认知水平、人力资本因素、科学技术水平、市场压力程度是影响富硒农产品区域品牌发展的主要因素。朱云芬、李卫东等人从宏观方面对硒产业发展进行了战略研究,但没有制定出富硒农产品品类含硒量的标准,也没有从互联网和供应链来研究富硒农产品。故本文从供应链和互联网角度来研究富硒农产品,通过互联网和供应链来发现富硒农产品在市场流通渠道中存在的问题,提出改进措施和相关建议,使成本降低,送货时间减少,增加配送效率,具有重要意义。
2、国内外普通农产品供应链
2.1国内农产品供应链
2.1.1农户+企业+中间商模式
传统农产品从生产者到加工企业再到一级销售商,一级销售商发给二级销售商,二级销售商提供给大型超市,大型超市供货给零售商和消费者,整个过程形成了完整的供应链,中间各环节实现紧密衔接。但产品层层流通,造成损耗,价格升高影响质量。在流通过程中物流全程参与,把企业和中间商视为不同节点,不同节点会有相同和不同的物流参与,导致双方成本增加,然而企业为转移额外费用会使农产品价格上涨。
2.1.2农户+产/销地+批发/中间商模式
农户种植,企业收购加工,流通到批发市场、菜场、超市,或直接供应超市与消费者对接,另一种是种植户以零售通过菜场来销售和消费者对接。该模式能减少农产品流通环节,加快其多渠道流通,加速多元化农产品向下游延伸,但该模式存在弊端,农户种植规模会对其流通有影响,当供应难以满足下游需求,农产品价格会升高,且流通周期会相应延长。
2.2国外农产品供应链

2.2.1美国:生产者+零售商+消费者模式
该模式为两种方式:第一是通过摊贩、小超市、各地社区或小型零售商店卖给消费者;第二是通过大型超市、当地机关或学校餐厅卖给消费者。该模式具有相对较低交易成本,销售农产品不经过多层级周转,因此货物流通快,耗时短,损耗小;产品不需多次加工和长时间运输,避免污染,其新鲜度高的特点。
2.2.2日本:批发+直销模式
该模式有两种,第一是批发模式,是指批发市场内农产品流通,中间涉及批发商、中间批发商及其他参加交易者,该模式承担了日本国内80%到90%的农产品交易量;第二是直销所模式,可以相对集中农产品的货源,充分展示其种类,并在很大程度上满足交易双方的买卖需求;还能综合各种渠道和信息资源,调整其供需平衡,有效避免农产品价格垄断,减少不必要损失。

3、富硒农产品供应链
3.1供应链现状
生产、加工企业受传统观念、资金规模和技术水平的制约,其产业发展主要集中在富硒农产品的生产和加工环节,并处于产业价值链上的低端。企业面临新技术研发、新工艺研究、经费投入不足等问题,很多富硒资源无法有效进行产业开发。目前国内多数企业生产设备老化,技术落后,产品质量低,创新能力不强。上游企业和中游企业、下游市场无法有效对接,资源难以整合,因为获利能力较低。
3.2优化供应链
企业设立门户网站,入驻网络平台。消费者通过网站和平台购买,第三方物流配送,有效减少富硒农产品流通层级。线下,消费者通过富硒农产品专卖店、大型超市、批发商来选购,不但节省时间,还能提高顾客满意度,对富硒农产品品牌建设具有很强的指导意义。企业利用网络平台、大数据等功能,整合信息资源挖掘潜在的客户,实现从上游到下游消费者的全程对接,有效避免因库存过多造成生产成本偏高。
4、总结
分析国内外普通农产品供应链的模式,在此基础上延伸到富硒农产品供应链,并从互联网角度来研究富硒农产品供应链,并对其流程改进和优化进行研究,从而在结构层面上解决阻碍富硒农产品发展的问题,对富硒农产品的研究还应该从宏观角度来研究,特别是政府政策的支持力度、资金、人才等层面。只有政府的政策支持,富硒农产品相关人才充足,企业生产环境良好,资金充裕,富硒农产品品牌建设有序不紊、富硒标准化研究不断深入,创新不断加强,富硒农产品会成为消费者心中的口碑产品。
最后努力把富硒农产品延伸到工业、旅游业,可以提高富硒农产品的附加值。不断加强与高校和科研院所合作,借助社会力量,将富硒产品向不同行业延伸,形成地域绿色、生态优势的“多元产业链”。整合富硒产业上、中、下游的资源实现配套衔接,打造优势互补、分工协作、布局合理、有竞争力的富硒产业链,实现从富硒供应链向富硒产业链转变。
参考文献:
[1]夏卫平,谭见安.中国一些岩类中硒的比较研究[J].环境科学学报,1990,10(2):125-131.
[2]廖启林,任静华,许伟伟等.江苏宜溧富硒稻米产区地质地球化学背景[J].中国地质,2016,43(5):1791-1802.
[3]张莹,刘桂建,郑刘根等.中国煤中硒的环境地球化学[J].矿物岩石地球化学通报,2007,26(3):389-398.
[4]冯彩霞,刘燊,胡瑞忠等.遵义下寒武统富硒黑色岩系地球化学:成因和硒富集机理[J].地球科学:中国地质大学学报,2010,35(6):948.
[5]赵婉彤,童建川,杨剑虹.重庆市江津区紫色土壤基本性质对土壤硒含量的影响[J].安徽农业科学,2017,45(5):92-95.
田凯.基于互联网视角下的富硒农产品供应链研究[J].农家参谋,2020(11):8.
继续阅读
- 暂无推荐
